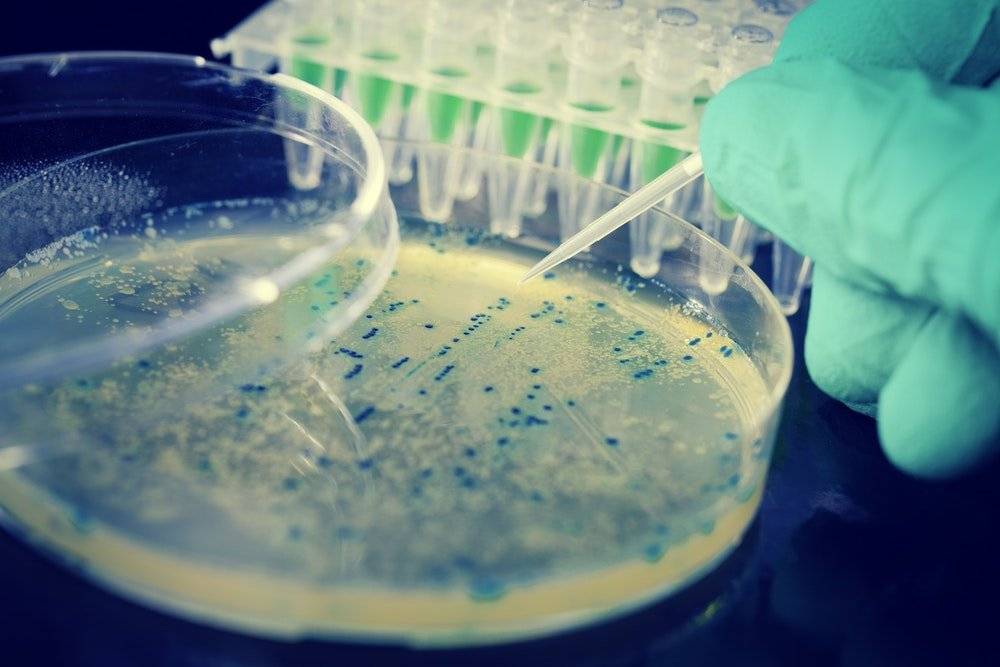

Губка для мытья посуды

Спустя 9 пунктов вы уже знаете, что к чему. Поэтому — сухие цифры. Страшные, сухие цифры.
Каждый грамм посудной губки — это больше 300 миллионов микроорганизмов.
Почти 80% губок могут «похвастаться» сальмонеллой, кишечной палочкой и фекальными бактериями. Почти 90% содержат плесень и дрожжи, почти 20 — стафилококк.
Губки рекомендуют менять каждый две недели. Почистить их можно водой с отбеливателем, либо прокипятив, либо несколько секунд подержав в микроволновке. С тряпкой для посуды аналогичная по всем пунктам история.
Понятно, что дома и стены помогают, и даже микробы — какие-то родные. Но всё же: не особо к ним привыкайте. И пожалуй, меняйте губку чаще двух раз в месяц.
А какие самые грязные места вы бы добавили к нашему списку? Редакция TheBiggest ждёт ваших комментариев.
Принцип работы бактерий для септика
Бактерии, находящиеся в упаковке, пребывают в состоянии спячки. Вместе с ними в упаковке содержаться все необходимые для их жизнедеятельности микроэлементы. Попадая в камеру септика, бактерии в течение нескольких часов начинают свою деятельность по переработке органической части сточных вод. Часть таких загрязнений преобразуется в жидкость, часть – выпадает в осадок. Эффективность микроорганизмов в септике напрямую зависит от постоянства пользования канализацией. Если воды поступает мало, то бактерии могут погибнуть. Идеально, чтобы над твердым осадком в септике было не меньше 2 см жидкости. То же самое касается и органических загрязнений – если они перестанут поступать в септик, то бактериям будет нечем питаться, и они станут менее эффективными.
В зависимости от формы выпуска биопрепарата (так называют бактерии с добавками и без них), его необходимо подготавливать к использованию. Биопрепарат в жидком виде взбалтывают, а в виде порошка или гранул разводят в воде. В любом случае необходимо руководствоваться инструкциями, указанным на упаковке.
Выгребная яма и однокамерный септик
Помимо станции биологической очистки или септика существует ещё несколько видов очистных сооружений, хотя, по факту, они не очищают стоки, а лишь собирают их в одном месте. К таким сооружениям относится выгребная яма и накопительный (однокамерный) септик. Как только яма или однокамерный септик заполняется стоками, необходимо их опустошить. Для этого на участок приезжает ассенизационная машина, откачивающая отходы из очистного сооружения.
Микроорганизмы, которые используются для многокамерных септиков, частично разлагают органическую часть загрязнений, расщепляют жиры, осветляют стоки, но, всё же, качество переработки хозяйственно-бытовых стоков будет не идеальной. Тем не менее, ассенизационную машину нужно будет вызывать не так часто, потому что отходы, которые не разложились до конца, будут скапливаться в специальном отсеке септика достаточно долгое время (от года до 3-х в зависимости от загруженности канализационной системы).
В однокамерных же септиках микроорганизмы всего лишь уменьшает неприятный запах, сопровождающий процесс гниения отходов. Т. к. камера всего одна и сточные воды не разделяются на жидкую и твердую фракции, их переработка не осуществляется. По принципу действия такой септик полностью копирует выгребную яму.
Очевидно, что стоимость автономной канализации частного дома, в основе которой выгребная яма или однокамерный септик, будет очень низкой, но и удобств при её эксплуатации и обслуживании не будет практически никаких.
Грязные вещи, которые мы используем каждый день, но редко чистим
Посуду и полы мы натираем дома очень часто, а вот различные гаджеты, речь о которых пойдет ниже, почему-то обходим стороной.
Несмотря на то, что все эти чудеса технического прогресса нельзя положить в посудомоечную или стиральную машины и не поместить под струю воды, чистить их все-таки время от времени просто необходимо. Например, на поверхности одного только сотового телефона находится не менее 17 000 различных бактерий.
1. Телефон
Этот гаджет является самым грязным предметом, используемым каждый день. Его нельзя протирать химическими или абразивными средствами, ведь их экраны чересчур деликатны. Эксперты предлагают проводить очистку телефонов водой с добавлением мыла. Для этого вы должны лишь слегка смочить любую мягкую ткань после чего приступать к аккуратному очищению.
Если вы находитесь в дороге или на рабочем месте, то в этом случае вам пригодятся антибактериальные влажные салфетки.
2. Ноутбук
Наверняка вы не разлучаетесь со своим ноутбуком даже во время принятия пищи, поэтому скорее всего, помимо пыли на нем имеются еще и крошки. Ноутбук способен собрать за короткий промежуток времени гигантское количество микробов.
Для очистки необходимо сперва его выключить и убрать из сети блок питания. Слегка сбрызнуть ватный тампон смесью из одинакового количества воды и уксуса
Обратите внимание, что сбрызнуть необходимо лишь слегка, чтобы тампон был немного влажным, а не полностью мокрым. После этого протрите всю поверхность ноутбука вместе с монитором.
3. Пульт управления
Знаете ли вы о том, что пульт управления является настолько грязным, что по наличию микробов он опережает даже кнопку сливного бачка в унитазе. Чистка пульта займет совсем мало времени.
Разбирать его для этой цели не нужно, достаточно протереть его поверхность смесью из воды и уксуса или воды и спирта. Следует также слегка сбрызнуть составом на салфетку или ватный диск и протереть поверхность. Расстояние между кнопочек можно очистить при помощи старой зубной щетки, которую также нужно обмакнуть в этот состав. Если вы будете время от времени очищать таким образом пульт, то вам не придется держать его в целлофане.
4. Клавиатура
Для того, чтобы очистить клавиатуру от различных крошек и скопления пыли, смешанной с жиром, эксперты советуют чистить ее с помощью сжатого потока воздуха или вакуумного шланга. Тампоном, немного смоченным в спирте, очень хорошо очищать пространство между клавишами.
5. Зарядное устройство
Вещь, к которой вы прикасаетесь не чаще, чем к сотовому телефону — это его зарядка. Для избавления от различных микробов потребуются антибактериальные салфетки. Протирайте ими блок питания от ноутбука и зарядное устройство для телефона не менее одного раза в неделю.
Посудомоечная машина
Остатки еды и известковые отложения от жёсткой воды очень часто можно обнаружить в посудомоечной машине. При длительных перерывах в использовании внутри машины может образовываться плесень. Чтобы предотвратить образование грибков и плесени, необходимо часто прочищать фильтр. Можно использовать специальные высокоэффективные реагенты, которые добавляются в машинку. Просто нужно запустить посудомоечную машину с этим реагентом на полный цикл работы, выставив самую высокую температуру. После завершения процедуры следует протереть внутренности машинки сухой тряпкой и оставить открытой до тех пор, пока она полностью не высохнет.
Хорошие и плохие бактерии
Бактерии — неотъемлемая часть нашей жизни. Они обитают на поверхности кожи, в ротовой полости, на гениталиях, в кишечнике и глазах, хотя ранее ученые думали, что глаза стерильны. Эти микроорганизмы появились задолго до нас, и в процессе эволюции человеческому организму пришлось научиться с ними сосуществовать.
Бактерии условно делятся на три типа: комменсальные, патогенные и оппортунистические. Комменсальные бактерии помогают иммунной системе распознавать болезнетворные микроорганизмы. Из-за этого они считаются хорошими.
Патогенные бактерии при попадании в организм способны вызывать заболевания. Эти бактерии могут распространяться через воду, воздух, почву, а также при физическом контакте. Сами по себе патогенные бактерии не представляют угрозу. Опасность возникает, когда их количество превышает норму, или если они оказываются не на своем месте.
Оппортунистические бактерии в условиях здоровой микробиоты не приносят ни пользу, ни вред. Однако они начинают активно размножаться при нарушениях в работе иммунной системы, заболеваниях, резких изменениях в составе микробиоты и травмах.
Staphylococcus aureus — типичные представители бактериального сообщества, носа и кожи. Но если они попадают в кровь, то способны спровоцировать инфекции.
Escherichia coli (E.coli) имеет плохую репутацию, связанную с пищевыми отравлениями. На самом деле, всего несколько представителей этого рода ответственны за это. Представленность E.coli в небольших количествах в кишечнике — норма. Однако, если они окажутся в мочевыводящих путях, это может стать причиной цистита.
Три экосистемы вашего дома

Отпечаток руки 10-летнего ребенка после прогулки во дворе
Дверная ручка
На дверной ручке испытуемых, проживающих вблизи парковых зон предсказуемо оказалась самая распространенная бактериальная ДНК растений. Хлоропласты – структуры, которые позволяют растениям извлекать энергию из фотосинтеза, изначально были свободно плавающими цианобактериями, которые поселились в растительных клетках. А вот обнаруженные ДНК цианобактерий – признак наличия в доме пыльцы.
Рядом с хлоропластами расположились кожные бактерии, в том числе из рода Corynebacterium (в него входят бактерия дифтерии). Ранее в 2010 году исследователи из Вустерского политехнического института в США обнаружили 1,32 тыс. бактериальных колоний на 27 дверных ручках при университетском кампусе.
Спальня

Так под микроскопом выглядит пылевой клещ
А вот результаты исследования 2016 года не столь оптимистичны: как оказалось, за 5-8 лет использования матраса в нем накапливается по меньшей мере 45 кг кожных роговых чешуек, и это не говоря о грибковых спорах и пылевых клещах.
Кухня
Кухонные бактерии, в свою очередь, были на 40% связаны с растениями или продуктами. Напомню, что ранее ученые подсчитали, что на поверхности деревянных разделочных досок обитает в 200 раз больше микробов, чем на ободке унитаза. Как думаете, какие бактерии обитают у вас дома? Ответ будем ждать здесь!
Результаты еще одного исследования показали, что губки для мытья посуды – самое настоящее биологическое оружие, если не менять их раз в неделю: из-за высокой влажности и постоянного контакта с остатками пищи в порах поролоновых губок образуются целые колонии микроорганизмов. Более того, в ходе исследования Национального научного фонда США (NSF) 86% губок и тряпок показали положительный результат на дрожжи и плесень. Кишечную палочку обнаружили в 75% образцов, еще в 18% — стафилококк.

Не исключено, что ваше недомогание может быть вызвано домашними бактериями и микроорганизмами
Игровые контроллеры и клавиатура
Джойстики для игровых приставок, компьютерная мышь, клавиши ноутбука – со всем этим мы соприкасаемся ежедневно, но дезинфицируем редко. Если экраны ПК и смартфонов очищаются хотя бы ради удаления пыли и жирных разводов, которые мешают обзору, то об устройствах ввода почти все забывают. Между тем на них 7,86 тыс. бактерий на 100 кв. см.

Чтобы защитить себя от воздействия бактерий, джойстики, клавиатуры, а также пульты ДУ и другие гаджеты и устройства нужно обрабатывать дезинфицирующей влажной салфеткой. Она не оставляет после себя влаги и безопасна при контакте с электронными устройствами.
Совет!
Перед началом обработки все же рекомендуется вытащить батарейки или отключить питание.
Получается, что самые опасные места – те, с которыми регулярно контактирует человек в процессе отдыха или приготовлении пищи.
Когда необходимо мыть руки
Целое скопище бактерий, вирусов и даже ДНК домашних животных сосредоточено на денежных банкнотах. И они остаются на наших руках после каждого посещения магазина, банка, аптеки. Не лучше дела обстоят и с банковской картой, которая переходит из рук в руки.
Также опасны поручни в общественных местах и транспорте. Только представьте масштаб путешествий вирусов и бактерий, поражающих людей в разных точках города, страны и даже мира. Чистые руки после транспорта должны стать для вас подсознательной привычкой.
Еще одна угроза здоровью — меню в заведениях общественного питания. Скорее всего, вообще никто не моет руки перед тем, как выбрать себе еду, только непосредственно перед процессом. Поэтому, сделав заказ, обязательно помойте руки!
Не забудьте вымыть их и после использования шариковой ручки либо карандаша в отделении банка, учитывая то, сколько у него клиентов. Опасны в этом смысле и мышка от компьютера, клавиатура и смартфон, которые находятся у нас в постоянном использовании. Дезинфицируйте их чаще.
К сожалению, наши питомцы тоже потенциальные разносчики инфекций, не говоря уже о бездомных животных. Уберегитесь от глистов, тщательно мойте руки после контакта с любимцами и не позволяйте им облизывать ваше лицо.
Благоприятной средой для размножения бактерий считаются влага и сырость. Поэтому следите за чистотой и сухостью на кухне. Тряпки, губки для мытья посуды и разделочные доски должны регулярно чиститься либо меняться на новые.
Логичным местом для обитания вирусов и бактерий можно назвать больницу и конкретно кабинет врача. В эти помещения постоянно приходят пациенты, а их болезни частично остаются на поверхностях. Поэтому руки следует мыть, как только уходишь из лечебницы.
Аэропорты и самолеты считаются самыми массовыми накопителями и распространителями бактерий. Подобно эффекту общественного транспорта, в них перемешивается зараза из разных регионов планеты, что особо опасно для человека со слабым иммунитетом.
Именно поэтому так важно знать, помнить и распространять информацию о болезнях грязных рук. Среди самых популярных специалисты выделяют дизентерию, гепатит А, эшерихиоз, глистные ивазии, грипп и ОРВИ, сальмонеллез, брюшной тиф и холеру
В первую очередь риску заразиться подвергаются люди со сниженным иммунитетом организма.
Как вы приучаете детей мыть руки? Как считаете, нужно ли это делать на государственном уровне? Делитесь полезной информацией с друзьями!
Предыдущая статья Следующая статья
Игрушки для животных
Недавнее исследование показало: квартиры с домашними животными содержат высокую концентрацию бактерий. Часть из них «живут» в корзине для игрушек: пушистые друзья человека «распускают слюнки» по предметам для игр, превращая их в парники для плесени, дрожжей и других бактерий.
Студентка полицейской академии Вьетнама рассказала, как ухаживает за кожей лица
Бразилец проезжает 36 км на велосипеде ежедневно, чтобы отвести любимую домой
Денежное дерево радует пышным цветением: мой секрет в уходе за листьями
Чтобы уничтожить возможное скопление бактерий, замочите резиновые игрушки в растворе, состоящем из одной части воды и одной части белого уксуса, на 5-10 минут, затем пропустите через посудомоечную машину и дайте высохнуть на воздухе. Выбросьте мягкие игрушки, если они порвались или стали дурно пахнуть.

Самые опасные для здоровья места в доме
1. Кухонные губки
Обычные губки для мытья посуды являются опасными рассадниками бактерий, поскольку постоянно контактируют с водой и долго сохнут. В них накапливаются частички еды, которая становится пищей для бактерий и грибка, а постоянная влажность создает еще более благоприятную среду для размножения микробов.
Чтобы исправить ситуацию, чаще меняйте губки либо стирайте их при температуре выше 60 градусов (разумеется, отдельно от вещей). Еще один лайфхак: если дома есть микроволновка, положите в нее губку на 1 минуту — это убьет бактерии.

2. Слив в кухонной раковине
В сливе всегда присутствует влага и остатки пищи, а значит и бактерии. Решить проблему можно с помощью специальных чистящих средств, обрабатывать которыми раковину следует минимум раз в неделю, а лучше через день.
3. Разделочные доски
Особенно активно размножаются бактерии на поверхности деревянных досок, поэтому лучше пользоваться пластиковыми либо керамическими изделиями. Только представьте, что на деревянной доске может находиться в 200 раз больше микробов, чем на сиденье унитаза. Идеальный вариант – использовать отдельные доски для каждой группы продуктов (мяса, рыбы, овощей и фруктов), а после применения обрабатывать уксусом 5%.
4. Холодильник и морозильная камера
Бактерии способны размножатся даже в условиях низких температур
Особое внимание стоит обратить на выдвижные ящики в холодильнике, где обычно хранятся овощи и фрукты, поскольку именно в этих местах чаще появляется плесень и убрать «причину» недостаточно, ведь грибковые пары с легкостью попадают на другие продукты, находящиеся рядом. Избавиться от бактерий позволяет регулярная обработка внутренней поверхности холодильника мыльным раствором и соблюдение срока хранения продуктов
В морозильной камере скапливается не меньшее количество микробов, поэтому также важно чистить внутреннюю поверхность мыльным раствором, минимум дважды в месяц и, разумеется, не стоит хранить в морозилке продукты не первой свежести
5. Ванная
Это помещение с повышенной влажностью, поэтому к уборке ванной комнаты стоит отнестись с особой ответственностью. Микробы скапливаются в углах, щелях, стыках между плитками, в сливах, на шторках. Для мытья ванны нужно использовать специальное дезинфицирующее средство, чаще проветривать помещение либо позаботиться об обустройстве хорошей системы вентиляции.
6. Зубные щетки
Щетки нужно обязательно мыть после использования, поскольку в нашей ротовой полости за ночь скапливается значительное количество бактерий, а утром мы можем перенести их на щетки.

7. Вентиляционные решетки
Многие не обращают внимания на состояние решеток, поскольку они расположены высоко. Но ведь именно на решетках созданы идеальные условия для жизнедеятельности бактерий. В доме лучше устанавливать съемные конструкции, которые следует снимать и протирать минимум раз в месяц.
8. Туалет
На стенах и полу в этой комнате больше микробов, чем на самом унитазе, ведь если сливать воду при открытой крышке унитаза, то все микроорганизмы из него легко попадают на пол и стены. Выход – всегда сливать воду при закрытой крышке и минимум раз в неделю мыть полы и протирать стены в туалетной комнате.
9. Ручки дверей
На ручках также скапливается множество вредоносных микроорганизмов, поэтому во время уборки обязательно следует протирать их салфеткой, смоченной в спирте.
10. Кровать
Наверняка вам известно о том, что в постельном белье живут пылевые клещи, которые могут спровоцировать различные проблемы со здоровьем. Чтобы избежать неблагоприятных последствий и обеспечить себе здоровый ночной отдых следует стирать постельное белье минимум раз в неделю при температуре не ниже 60 градусов.
11. Одежда
Одежду стирать нужно также часто, как и постельное белье, поскольку и то и другое соприкасается с телом и быстро накапливает бактерии. Относите вещи в быструю чистку, даже если они кажутся чистыми, но их носили несколько дней.
12. Гаджеты
Это не только смартфоны, но и планшеты, компьютерные мыши, клавиатуры и прочие вещи, к которым вы часто прикасаетесь. Их следует регулярно протирать специальными салфетками.
Не забывайте о генеральной уборке, которую нужно проводить каждый месяц
Уделяйте внимание таким участкам под кроватями и шкафами, нишам и полкам, где скапливается большое количество пыли и соответственно, микробов. Чистое жилье – залог вашего здоровья!опубликовано econet.ru
Подписывайтесь на наш youtube канал!
P.S. И помните, всего лишь изменяя свое потребление — мы вместе изменяем мир! econet
Где больше всего бактерий на теле человека
Недавно исследователям удалось установить, где больше всего бактерий живет на человеческом теле. Результаты сильно удивили, так как это оказались даже не подмышки, о которых говорили ранее, а участки рук от запястья до локтя. Именно на этом участке кожи ученым удалось обнаружить 44 вида бактерий.
Условия исследования предполагали, что все участники эксперимента будут на протяжении недели мыться одинаковым мылом, а в последний день не мыть вообще. После этого они дали исследователям возможность взять мазки со всех частей тела для сравнения. Результатом эксперимента стало обнаружение около 100 разнообразных микроорганизмов. При этом больше всего разных бактерий было найдено на участке кожи от запястья до локтя. Такое положение вещей, скорее всего, связано с тем, что эта часть рук часто соприкасается с другими предметами. При этом мало кто моет руки до локтей также часто, как и ладошки.
Удивило ученых и то, что на жирных участках кожи бактерий оказалось ничуть не больше, а даже меньше, чем на сухих. А самой чистой оказалась кожа за ушами. В этом месте живет не более 15-ти видов бактерий.
Пульт от телевизора

Особо не злорадствуйте, если не смотрите телевизор: предметов, которые все члены семьи трогают по сто раз на дню в вашем доме предостаточно. На выключателях, конечно, микробов гораздо меньше. А вот общая на всех клавиатура компьютера или тот же пульт от кондиционера — вещи кишащие.
Пульт приятнее для бактерий за счёт бешеного «трафика» рук, в которых он бывает, кучи кнопочек с прорезями вокруг каждой; особенно если кнопки мягкие. Больше половины рандомно проверенных пультов дистанционного управления содержали не видимые глазу дрожжи и плесень. Так себе соседи к вашему чаю под вечернюю передачу.
Благо — очищение пульта не требует разбора по кнопочкам. Достаточно готовой дезинфицирующей салфетки или собственного антисептика (спирт с водой). Рекомендуется также протирать отсек для батареек.
3
Компьютерные мыши и клавиатуры
Едва ли вы задумываетесь о микробах на ваших вещах, которыми вы пользуетесь каждый день. Например, о мыши и клавиатуре компьютера, которые используются в наше время, пожалуй, больше других вещей. Причем, именно их люди чистят либо крайне редко, или вообще никогда.
 Фото: www.yurtopic.com
Фото: www.yurtopic.com
Как результат, возле вашего компьютера размножается огромное число болезнетворных микроорганизмов. Безусловно, здесь играет большую роль частота и усердность чистки
Это действительно важно, поэтому не торопитесь и делайте это тщательно. Спреи в данной ситуации использовать нельзя, поэтому единственный выход – использование ватных палочек, смоченных в дезинфицирующей жидкости, чтобы можно было тщательно прочистить пространство между кнопками клавиатуры
 Фото: www.yurtopic.com
Фото: www.yurtopic.com
Как и все остальное, компьютерную клавиатуру и мышь рекомендуют чистить не реже раза в неделю.
Интересные факты о бактериях
- Офисный стол заселен бактериями в 400 раз больше, чем туалет. Если за офисным столом принимать пищу, то это усугубляет ситуацию.
- Во рту человека бактерий больше, чем население всей планеты.
- На вес бактерий в организме человека приходиться около 1, 8 кг.
- После дождя активируются бактерии, которые и образуют свежий запах.
- Мобильные телефоны населены бактериями гуще в 18 раз, по сравнению с ручкой сливного бочка.
- При взаимодействии бактерий, находящихся на коже человека, образуется неприятный запах.
- Даже после чистки зубов на каждом зубе человека может находится до 100 тысяч бактерий.
- Шоколад не вызывает кариес, а наоборот, обладает антибактериальным эффектом.
- Даже в хлорированной воде через полгода начнут размножаться бактерии, если процедуру хлорирования не повторить.
- На купюре 1$ может находиться около 3000 одних только видов бактерий.
- Антибиотики изготовляются из бактерий.
Зная самые популярные места скопления бактерий, человек может чаще подвергать их дезинфекции или избегать с ними контакта. Уменьшение контакта с бактериями минимизирует риск возникновения заболеваний, а это значит, что сохраняет здоровье человека.
Результаты научной работы
Исследователи обнаружил, что в детском саду, четыре из пяти игрушек, а также на поверхности детских кроваток, выявлялись S. Pneumoniae и S. Pyogenes. Тестирование было сделано незадолго до открытия детского сада утром, так что прошло много времени с момента последнего контакта с людьми.
Anders Hakansson с соавторами заинтересовались возможностью некоторых бактерий сохранять свою жизнедеятельность на поверхностях долгое время. Ученые выяснили, что бактерии образуют биопленки, которые колонизируют человеческие ткани и становятся более выносливее, чем другие формы бактерий.
Эмперическим путем выявлено, что месячные биопленки S. pneumoniae и S. Pyogenes с загрязненных поверхностей легко приживаются у мышей. Биопленки выживали на человеческих руках в течение часа и сохраняются на предметах, даже после тщательного очищения.
Исследователи обнаружили, что патогены могут выжить в течение длительного времени вне живого организма, но заразиться вы можете, только вдыхая зараженные капельки при кашле и чиханий зараженного человека.
Hakansson предупреждает, что надо провести много исследований, чтобы понять при каких обстоятельствах этот тип контакта приводит к распространению инфекций между людьми. Ведь обычно обрабатываются предметы загрязненные этими биопленками, и которые являются резервуаром для бактерий в течение длительного времени.
По мнению Hakansson «если выяснится, что этот тип распространения является значимым, то надо будет проводить те же мероприятия, которые предотвращают распространения других бактерий, такие как кишечные бактерии и вирусы».
Почему именно кишечник
Задача кишечника — впитать максимальное количество полезных веществ, а для этого нужна большая площадь поверхности. Чтобы ее уместить, строение кишечника представляет собой плотно прилегающие друг к другу складки с ворсинками и микроворсинками. Из-за этого кишечник часто сравнивают с бархатной тканью.
Поверхность кишечника покрыта слизистым слоем — муцином. Он защищает клетки кишечника от агрессивных представителей микробиоты. Муцин обновляется каждый час, так как часть этого слоя уносят фекальные массы по мере продвижения по кишечнику.
Влажная, теплая среда с большим количеством складок и отростков — идеальная среда для роста бактерий. Возможно, вы слышали миф, что количество бактерий в 10 раз превышает количество клеток в теле человека. В организме человека весом 70 килограмм и ростом 170 сантиметров содержится около 30 триллионов клеток и 39 триллионов бактерий кишечника. Хотя отношение не 1:10, число все равно впечатляющее.
Насадки для душа
Большинство людей принимают душ каждый день. Немногие из них знают, что эта привычка может повысить риск легочных и сердечных заболеваний. Это может произойти во время случайного заглатывания либо вдыхания воды вместе с бактериями, расположенными в насадке для душа.
 Фото: www.yurtopic.com
Фото: www.yurtopic.com
В 2013 году американские ученые обнаружили, что в 30% исследованных насадок для душа высоко число болезнетворных бактерий. Причем, там их может быть в сотни раз больше, чем в кранах по всему дому. Здоровым людям едва ли грозит серьезное заболевание – а вот людям с ослабленным иммунитетом стоит быть осторожнее.
Снизить риск можно, если включать воду примерно на минуту раньше того, как начнете принимать душ. Кроме того, необходимо регулярно чистить насадку для душа. Можно полностью разобрать ее и оставить на 20 минут в кипятке.
 Фото: www.yurtopic.com
Фото: www.yurtopic.com
Еще вы можете вымочить ее несколько часов в уксусе (лучше оставить на ночь). Делать это рекомендуется не реже раза в месяц.
Как улучшить показатели микробиоты
Когда мы говорим о главных органах, которые влияют на здоровье, первое, что приходит на ум — сердце, легкие, печень, мозг. О кишечнике часто думают в последнюю очередь. Но все больше исследований говорит о том, что этот орган отнюдь не второстепенный, и может даже влиять на настроение и качество сна. На здоровье микробиоты влияет несколько факторов.
Питайтесь с заботой о бактериях кишечникаКлючевые слова, которые связывают здоровье микробиоты и питание — разнообразие и умеренность. Следующие продукты помогут поддерживать здоровье микробиоты:
- Продукты растительного происхождения: овощи, зелень, цельнозерновые продукты, орехи, семена, фрукты, растительные масла. Это богатые источники клетчатки, пребиотиков и ненасыщенных жирных кислот.
- Жирная рыба и морепродукты: источники белка, ненасыщенных жирных кислот.
- Пробиотики: кефир, йогурт, комбуча, квашеная капуста. Содержат полезные бактерии и увеличивают разнообразие микробиоты.
На здоровье пищеварения влияет не только тип еды. Количество еды, частота и время приема пищи тоже отражаются на состоянии ЖКТ. Старайтесь не переедать, избегайте снеков, особенно полуфабрикатов, не ешьте на ночь. Ваш кишечник тоже должен отдыхать и успевать справляться с поступающей пищей.
Больше двигайтесьДоказано, что занятия спортом положительно влияют на бактериальный состав микробиоты. И наоборот, при сидячем образе жизни, разнообразие снижено. Это может вызывать дисбиоз и снижение иммунитета. Исследования показывают, что даже 20-минутная прогулка после приема пищи улучшает пищеварение.
Избегайте стрессКогда вы испытываете стресс, страдает и микробиота вашего кишечника. И наоборот, скудный состав микробиоты может вызвать негативные изменения в вашем психологическом состоянии. Высыпайтесь, занимайтесь йогой или медитацией, гуляйте на свежем воздухе, уделяйте время любимому хобби.
Результаты Теста микробиоты Атлас помогут узнать, какие виды бактерий населяют кишечник, как микробиота справляется с синтезом витаминов или масляной кислоты, а также степень защиты от заболеваний. Используйте промокод blog10, чтобы получить скидку 10% на исследование.
Запомнить:
- Кишечные бактерии учат иммунитет распознавать патогены.
- Сбалансированное бактериальное сообщество защищает организм от развития некоторых хронических заболеваний.
- Дисбиоз — негативные изменения в микробиоте, которые могут вызвать воспаление.
- Естественные роды могут способствовать знакомству ребенка с бактериями и улучшать иммунитет.
- Тестирование микробиоты кишечника помогает оценить состояние микробиоты.
- C Mueller and A J Macpherson. Layers of mutualism with commensal bacteria protect us from intestinal inflammation. Gut, 2006.
- Fabien Magne, Alexa Puchi Silva, Bielka Carvajal, and Martin Gotteland. The Elevated Rate of Cesarean Section and Its Contribution to Non-Communicable Chronic Diseases in Latin America: The Growing Involvement of the Microbiota. Frontiers in Pediatrics, 2017.
- LF Stinson et al, A Critical Review of the Bacterial Baptism Hypothesis and the Impact of Cesarean Delivery on the Infant Microbiome, 2018
- S. Banquera et al., Global Overview of the Epidemiology of Atherosclerotic Cardiovascular Disease, 2015
- J. Zhuye et al., The gut microbiome in atherosclerotic cardiovascular disease, 2017
- C. Bogiatzi et al., Metabolic products of the intestinal microbiome and extremes of atherosclerosis, 2018
- NA. Molodecky et al. Environmental Risk Factors for Inflammatory Bowel Disease
- J E Mawdsley and D S Rampton, Psychological stress in IBD, 2005
- S. Khanna & LEH Raffals, The Microbiome in Crohn’s Disease. Role in Pathogenesis and Role of Microbiome Replacement Therapies, 2017
- V. Pascal et al., A microbial signature for Crohn’s disease, 2017
- Ting-Ting Huang et al, Current Understanding of Gut Microbiota in Mood Disorders: An Update of Human Studies, 2019
Плесень и аллергия
Плесневые грибы активно размножаются в условиях повышенной влажности в сочетании с комфортной комнатной температурой (22-25°С). При этом возможно развитие у человека аллергии к низшим грибам (плесневые грибы и дрожжи) или грибковых поражений ногтей и кожи. Фактически такая аллергия чаще формируется у жителей первых и последних этажей. Связано это с тем, что нижний этаж соседствует с подвалом, а верхний — с кровлей. И то, и другое предполагает попадание теплого влажного воздуха.
Больше этих микроорганизмов в домах из дерева, чем из бетона. В квартирах их особенно много в мягкой старой мебели, перьевых подушках, на занавесках для душа, в сантехнике, в местах водопроводных протечек, в птичьих клетках и т. д. Плесень колонизирует не только натуральные, но и синтетические материалы, даже пластмассу. При наличии большого количества растений число грибных спор возрастает, что в большей степени связано с поливом и опрыскиванием «зеленых» друзей. Грибы могут развиваться в кондиционерах и увлажнителях воздуха.

























































